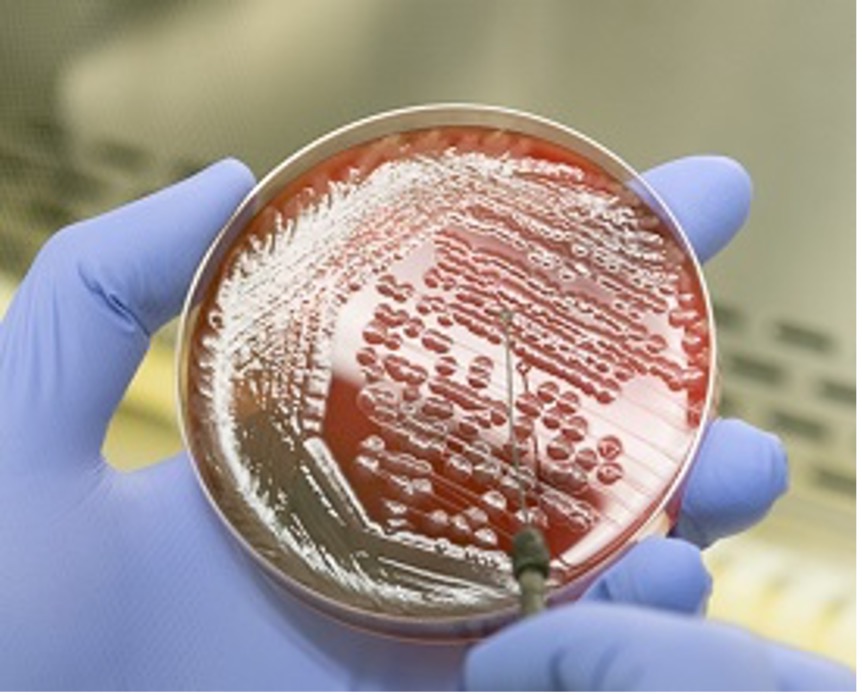
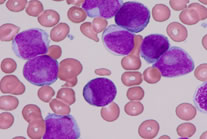
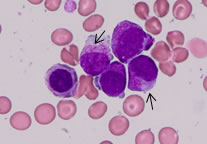
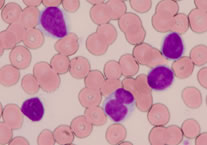

臨床検査センター
臨床検査センターについて
検査基準値(2025.4.30更新)
臨床検査センターの業務は、血液などから検査する化学、免疫、血液、一般、微生物、輸血の検体検査部門と組織などを検査する病理、細胞診、遺伝子の病理検査部門に分かれています。
これらの検査は、病気の診断はもちろんですが、その後の治療方針を決める際にも大きな手助けとなります。そのためには、迅速な検査と正確な検査が要求され、精度管理を定期的に実施し常に精度の高い検査を心がけています。また患者さんを中心としたチーム医療にも積極的に関わり、より良い医療サービスが提供できるよう、開かれた臨床検査センターを目指して取り組んでいます。
検体検査部門
病理検査部門
微生物学的検査(微生物検査室)
微生物学的検査は、感染症の原因となっている細菌や真菌(カビ)を見つけ出し、その菌にどのような抗菌薬がよく効くかを調べる検査です。
検査の手順
検査材料
気管支や肺の病気が疑われる時には喀痰を、感染性腸炎(感染性下痢症)が疑われる時には便を、膀胱炎や尿道炎が疑われる時には尿、敗血症(体の中に細菌感染巣があり血液中に菌が侵入する病態)が疑われる時には血液など、患者さんに由来するあらゆるものが検査材料となります。
塗抹・顕微鏡検査
検査材料を直接スライドガラスに塗りつけ、グラム染色という染色をします。それを顕微鏡で観察して菌の存在の有無を調べ、菌の形態の特徴などから菌種の推定を行います。検査材料が検査室に届いてから1時間以内に報告をしています。
 |
 |
左の写真は、グラム染色したスライドを顕微鏡(1000倍)で観察したものです。 患者さんの咽頭粘液から、肺炎球菌が検出されました。 |
| ↑鏡検の様子 |
|---|
分離培養・同定検査
栄養分を含んだ寒天(培地)に検査材料を塗って培養を行います。材料の種類、予想される目的菌によって、培地、培養時間、培養環境を選択します。発育してきた菌の形、性質などにより何菌なのかを調べて(同定)、種々の同定用培地、または自動機器によって菌の名前を決定します。
薬剤感受性検査
菌の名前が決定されると、どのような薬剤が効くのか、効かないのかを調べて判定します。
その他の検査
迅速検査(抗原検出・毒素検査)
培養検査を行わず、細菌・ウィルスの抗原や毒素を検出をする検査です。
下痢の原因となるノロウィルス抗原、肺炎の原因となるインフルエンザウイルス抗原や肺炎球菌抗原、また細菌の出す毒素検査(CDトキシン)などがあります。
尿素呼気試験
ヘリコバクターピロリ菌の消化管内感染の有無を調べる検査です。診断薬服用前後の患者さんの呼気を採取して行います。詳しい内容はこちら(尿素呼気試験について)をご覧ください。
微生物検査室の取組み
- 感染対策チーム(ICT)や抗菌薬適正使用支援チーム(AST)の一員として病棟ラウンドなどを行い、院内の感染対策及び抗菌薬の適性使用のための活動に取り組んでいます。
- 毎月行われる院内感染対策委員会には感染症発生状況や薬剤耐性菌の分離頻度等のデータを提供しています。
- 検査室内だけではなく、病棟や外来に出向いて直接患者さんの検体を採取することもあります。より迅速で、精度の高い結果報告に繋がっています。
輸血検査室

輸血検査室では、病気や治療で輸血が必要になった患者さん一人一人に対して、より安全で最適な輸血を実施するために、次のような業務を行っています。
輸血に関する検査
| 1.血液型検査 | ABO式血液型と、Rh式血液型を調べる検査です。 |
|---|---|
| 2.不規則抗体検査 | 輸血や妊娠などで、赤血球に対する抗体が産生された場合、輸血した血液が凝集したり血液を溶かしたりする(溶血)ことがあります。このような抗体(=不規則抗体)が体の中に存在していないかどうかを調べる検査です。 |
| 3.交差適合試験 | 輸血を受ける患者さんの血液と、輸血用血液製剤の血液を、試験管などの中であらかじめ混合し、凝集や溶血が起きないかを調べ、適合性を確認する検査です。安全な血液製剤を患者さんに届けるために、とても大切な検査です。 |
輸血用血液製剤の管理
当センターでは2008年3月より、以下に示す輸血用血液製剤や血漿分画製剤が適正に使われるように、輸血検査室が製剤の発注、保管、払い出し等を一元的に管理しています。
血液製剤
赤血球製剤(Ir-RBC-LR):主に貧血を改善するために使用します。
血小板製剤(Ir-PC-LR):止血・出血防止のために使用します。
新鮮凍結血漿製剤(FFP-LR):凝固因子の補充のために使用します。
血漿分画製剤
アルブミン製剤、グロブリン製剤、アンチトロンビンIII製剤、フィブリン糊製剤
血漿は、各種のタンパク質と、ブドウ糖、脂質、金属イオン、電解質、ホルモン、ビタミンなどを含んだ液体です。そのうち、特に重要な「タンパク質」を成分ごとに精製したものが「血漿分画製剤」と呼ばれるものです。
末梢血幹細胞採取と保管管理
造血幹細胞とは血液の成分である赤血球や白血球などの元になる細胞で、普段はほとんどが骨髄中にあります。この骨髄にある造血幹細胞をG-CSFという薬剤を投与することにより大量に作り出します。そして骨髄から血液中にあふれ出た造血幹細胞をできるだけ他の血液成分を除いた形で採取します。この採取した末梢血幹細胞を調製、凍結保存し、移植する日まで適切な温度管理のもと保存・管理しています。
自己血輸血
あらかじめ自分の血液を貯めておいて使う輸血方法です。そのため輸血副作用の危険はありません。全身状態が良好な患者さんで、出血することが予想される手術やまれな血液型の患者さん、不規則性抗体を持っている患者さんが適応となります。担当医にご相談ください。
適正輸血と安全確保のための取り組み
輸血は、患者さんに十分な説明と同意をいただいた上で実施されます。輸血検査室では、事前に検査した患者さんの血液型や不規則抗体の有無、輸血歴等の情報をもとに交差適合試験を行い、患者さんに最適な血液製剤を選択します。輸血検査室では、迅速で安全な輸血ができるよう最大の努力をしています。
また、輸血用血液製剤は、献血者の善意により供給されていることを念頭に置き、無駄のない適正な輸血がされるようセンター内に注意喚起をしています。
検体検査
検体検査では患者さんから採取された検体(血液や尿、穿刺液など)を用いて分析・検査を行っています。主要な検査項目については診察前検査として迅速に検査する体制を取っており、60分以内に結果を報告しています。一部の特殊検査や精密検査の中には、外部の検査センターに依頼しているものもあります。これらの検査については内部・外部精度管理 を通じて常に高い精度を保つよう努めております。生化学検査、免疫血清検査、血液検査、一般検査)
臨床化学検査(生化学検査)
臨床化学検査は、体内の酵素、脂質、含窒素成分、電解質、糖の代謝などの検査です。
これらの検査は、病気の診断や治療効果の判定などに用いられます。

酵素活性検査(ALP、LDH以外はJSCC法)
| 検査項目 | 基準値 | (単位) | この検査でわかること |
|---|---|---|---|
| ALP(IFCC) (アルカリフォスファターゼ) |
38~113 | U/L | 肝・骨・胎盤・小腸の働きに関係がある酵素で肝・胆道疾患や骨の病気などで高値になります。 |
| AST (アスパラギン酸アミノトランスフェラーゼ、GOT) |
13~30 | U/L | ASTは肝・骨格筋・心筋・腎・赤血球など、ALTは肝・腎・心筋など多くの臓器組織細胞中に含まれています。これらの臓器が障害された際、血液中に 出てくるため高値になります。ALTはASTに比べて肝(障害)に特異性が高いといわれています。ASTは骨格筋にも多く含まれているので筋肉運動でも高値になります。 |
| ALT (アラニンアミノトランスフェラーゼ、GPT) |
♂ 10~42 ♀ 7~23 |
U/L | |
| LDH (乳酸脱水素酵素) |
124~222 | U/L | あらゆる組織、特に、心臓の心筋・肝臓・腎臓・骨格筋・血球に多く含まれています。これらの臓器に炎症や組織障害が起きると高値になります。 |
| CHE (コリンエステラーゼ) |
♂ 240~486 ♀ 201~421 |
U/L | 肝臓で合成される酵素で、主に肝臓が障害を受けると低値になります。高脂血症・脂肪肝・ 肥満などで高値になります。 |
| LAP (ロイシンアミノペプチダーゼ) |
30~70 | U/L | 様々な臓器や胆汁中に広く分布する酵素です。肝・胆道系疾患や、血液疾 患・感染症などで高値となります。 |
| Y-GTP (Y-グルタミルトランスフェラーゼ) |
♂ 13~64 ♀ 9~32 |
U/L | 肝臓・胆道系の機能を調べる検査です。肝障害、飲酒で高値となります。 |
| CPK または CK (クレアチンキナーゼ) |
♂ 59~248 ♀ 41~153 |
U/L | 筋肉の収縮に関係する酵素で、筋肉・脳に多く含まれています。これらの組織・細胞に炎症(障害)があると高値になります。また、ステロイド治療や妊娠でも高値となる場合があります。 |
| AMY (アミラーゼ) |
44~132 | U/L | 膵臓や唾液腺より分泌される消化酵素です。慢性・急性膵炎や耳下腺炎で高値となります。 |
脂質検査
| 検査項目 | 基準値 | (単位) | この検査でわかること |
|---|---|---|---|
| TC (総コレステロール) |
142~248 | mg/dL | 主に肝臓で作られるため、肝臓の働きや栄養状態の目安となります。食生活や女性ホルモンにより変動します。動脈硬化性疾患や糖尿病などで高値になることがあります。 |
| TG (中性脂肪) |
♂ 40~234 ♀ 30~117 |
mg/dL | 動脈硬化性疾患の危険因子といわれています。食事により高値となりますが、特に脂肪の多い食事で高値となります。肝障害や、栄養状態の悪化で低値となります。 |
| HDL-C (HDLコレステロール) |
♂ 38~90 ♀ 48~103 |
mg/dL | “善玉コレステロール”とも呼ばれ、低値は動脈硬化性疾患の危険因子とされています。習慣的な運動で高値となり、肥満・喫煙などで低値となります。 |
| LDL-C (LDLコレステロール) |
65~163 | mg/dL | “悪玉コレステロール”とも呼ばれ、高値は動脈硬化性疾患の危険因子とされています。糖尿病・肥満で高値となり、肝機能の悪化で低値になります。 |
含窒素成分検査
| 検査項目 | 基準値 | (単位) | この検査でわかること |
|---|---|---|---|
| UN (尿素窒素) |
8.0~20.0 | mg/dL | 蛋白質が代謝された最終物質であり、肝臓・腎臓が関与しています。高蛋白食・代謝性疾患・腎機能・火傷で高値になります。また、肝機能障害で低値となります。 |
| CRE (クレアチニン) |
♂ 0.65~1.07 ♀ 0.46~0.79 |
mg/dL | 腎臓の機能が低下するとCREは高値になります。食事などの影響を受けないため腎機能のすぐれた指標になります。 |
| UA (尿酸) |
♂ 3.7~7.8 ♀ 2.6~5.5 |
mg/dL | 魚介・肉・豆類などたんぱく質の豊富な食物にはプリン体が多く含まれています。このプリン体の最終産物(老廃物)が尿酸です。尿酸が増えすぎると痛風の原因になります。 |
| NH3 (血中アンモニア) |
12~66 | μg/dL | アミノ酸が肝臓で尿素になる過程の物質です。肝機能に障害があると高値となります。また、消化管の大量出血でも高値となります。 |
| T-BIL (総ビリルビン) |
0.40~1.50 | mg/dL | ビリルビンは赤血球中のヘモグロビンが分解してできる黄色い色素です。肝臓・小腸がビリルビン代謝に関係しているため、肝臓・胆管・消化管機能の悪化により高値となります。また、血液疾患でも高値となる場合があります。 |
| D-BIL (直接ビリルビン) |
~0.40 | mg/dL |
電解質・無機物検査
| 検査項目 | 基準値 | (単位) | この検査でわかること |
|---|---|---|---|
| Na (ナトリウム) |
138~145 | mmol/L | 体液の量や浸透圧の調節をします。欠乏すると脱水症、過剰になると浮腫(むくみ)の原因になります。 |
| K(カリウム) | 3.6~4.8 | mmol/L | 神経細胞の働きや筋肉の収縮に関与しています。腎不全などで高値、嘔吐・下痢などで低値を示します。 |
| Cl (クロール) |
101~108 | mmol/L | 体の酸塩基平衡や浸透圧を調節します。水分の代謝異常(浮腫・嘔吐・下痢等)や酸塩基平衡異常の疑いがある場合に検査します。 |
| Ca (カルシウム) |
8.8~10.1 | mg/dL | 骨代謝やホルモンの分泌や生成に関与しています。副甲状腺や骨疾患・腎不全などで異常値を示します。副甲状腺機能低下症・腎機能低下などで低値となり、副甲状腺機能亢進症・骨破壊などで高値となります。 |
| P (無機リン) |
2.7~4.6 | mg/dL | 内分泌・骨代謝に異常がないかを調べる検査です。 |
蛋白検査
| 検査項目 | 基準値 | (単位) | この検査でわかること |
|---|---|---|---|
| TP (総蛋白) |
6.6~8.1 | g/dL | 栄養状態と肝臓・腎臓機能を反映しています。肝硬変などの低蛋白血症で低下し、脱水や多発性骨髄腫で上昇します。 |
| ALB (アルブミン) |
4.1~5.1 | g/dL | 肝臓で合成される水溶性の蛋白質です。栄養状態の悪化や肝障害の程度を反映して低下します。 |
| A/G (アルブミン対グロブリン比) |
1.32~2.23 | 血清中の蛋白であるアルブミン(A)とグロブリン(G)の比率で、様々な病態を推測することに役立ちます。 | |
| CRP (C反応性蛋白) |
0.14以下 | mg/dL | 炎症やからだの組織が壊れた場合に増える蛋白質で、回復とともに減少するので炎症症状の目安となります。 |
金属検査
| 検査項目 | 基準値 | (単位) | この検査でわかること |
|---|---|---|---|
| Fe (血清鉄) |
40~188 | μg/dL | 貧血の病態把握に用いられます。鉄欠乏貧血・感染症などで低値となり、肝障害などで高値となります。鉄は赤血球のヘモグロビンのもとになる成分です。 |
| Mg (マグネシウム) |
1.8~2.4 | mg/dL | DNA、RNAの合成や神経・筋における情報伝達の役割をします。腎障害・脱水などで高値、慢性下痢などで低値となります。 |
糖代謝検査
| 検査項目 | 基準値 | (単位) | この検査でわかること |
|---|---|---|---|
| 血糖 (グルコース) |
73~109 | mg/dL | 血糖とは血液中のブドウ糖のことです。糖尿病発見の手がかりになります。食事によって変動(食後は上昇)するため通常は空腹時に採血します。 |
| HbA1c(NGSP) (グリコヘモグロビンA1c) |
4.9~6.0 | % | 糖尿病がどの程度コントロールできているかを調べる検査です。過去1~2ヶ月の血糖状態を反映しています。採血時の食事の影響は受けません。 |
機能検査
| 検査項目 | 基準値 | (単位) | この検査でわかること |
|---|---|---|---|
| ICG停滞率 (インドシアニングリーン試験) |
10以下 | % | 肝機能検査のひとつで肝硬変の診断や肝予備能の評価、肝切除術の術前検査に用いられます。検査の前、12時間は水・お茶以外の飲食をしないでください。 |
| ICG消失率 (インドシアニングリーン試験) |
0.168~0.206 | ||
| CCR24時間法 (クレアチニンクリアランス) |
♂ 62~108 ♀ 57~78 |
ml/min | 腎機能検査のひとつで腎障害の程度を知る目安となります。 |
免疫血清検査
免疫血清検査は、がん細胞が多く生み出す特殊な物質(腫瘍特異物質)、甲状腺ホルモン、感染症の有無を調べる抗原や抗体(感染症関連物質)などの検査です。

腫瘍特異物質検査 がんの存在と推移を知るのに役立ちます。
| 検査項目 | 基準値 | (単位) | この検査でわかること |
|---|---|---|---|
| CEA | 5.0以下 | ng/mL | 甲状腺・胃・大腸・肺・子宮・その他の多くの臓器のがんの他、肺炎・肝硬変・膵炎・結核・糖尿・腎不全・喫煙などで上昇することがあります。 |
| CA125 | 35.00以下 | U/mL | 卵巣・子宮・膵臓・肺・大腸などのがんや子宮内膜症、良性の卵巣腫瘍などで上昇することがあります。 |
| CA15-3 | 28.0以下 | U/mL | 乳がん・卵巣がん、良性の乳腺疾患などで上昇することがあります。 |
| AFP | 10.0以下 | ng/mL | 肝細胞がん・肝炎、肝硬変などで上昇することがあります。 |
| CA19-9 | 37.0以下 | U/mL | 膵臓・胆のう・胃・肝臓・大腸・肺・卵巣など多くの臓器のがんや膵炎、肝炎などで上昇することがあります。また、胃薬などで上昇する場合があります。 |
| PSA | 4.00以下 | ng/mL | 前立腺がんの他に、前立腺の炎症・前立腺肥大で上昇することがあります。また、育毛剤で上昇することがあります。 |
| SCC | 1.5以下 | ng/mL | 子宮・食道・肺などのがんや、気管支などの上気道疾患などで上昇することがあります。 |
甲状腺ホルモン検査 甲状腺の病気の種類や程度を調べる検査です。
| 検査項目 | 基準値 | (単位) | この検査でわかること |
|---|---|---|---|
| TSH (甲状腺刺激ホルモン) |
0.35~4.94 | μIU/mL | 甲状腺ホルモン(FT3、FT4)は下垂体の甲状腺刺激ホルモン(TSH)の働きにより血液中に分泌され、代謝に重要な働きをしています。過剰に分泌されると甲状腺機能亢進症、分泌が少ないと甲状腺機能低下症になります。 |
| FT3 (遊離トリヨードサイロニン) |
1.68~3.67 | pg/mL | |
| FT4(遊離サイロニン) | 0.70~1.48 | ng/mL |
感染症関連物質検査
| 検査項目 | 基準値 | この検査でわかること |
|---|---|---|
| RPR定性 | (-) | 梅毒感染の有無を調べる検査です。 ただし、RPR定性は肝疾患や感染症、自己免疫性疾患などで陽性(生物学的偽陽性)になることもあります。 |
| TPHA定性 | (-) | |
| HBs抗原 | (-) | B型肝炎ウイルス感染の有無を調べる検査です。 |
| HCV抗体 | (-) | C型肝炎ウイルス感染の有無を調べる検査です。 |
| HIV抗原・抗体 | (-) | AIDS(後天性免疫不全症候群)の原因ウイルスであるHIV感染の有無を調べる検査です。 |
血液検査
血液検査は赤血球数・白血球数・血小板数の測定、血液細胞の形態観察、出血傾向の有無などを検査しています。これらは、貧血、炎症、血栓症、白血病などの病気の診断・経過観察に用いられます。

末梢血液検査 貧血や感染症の有無などを調べる検査です。
| 検査項目 | 基準値 | (単位) | この検査でわかること |
|---|---|---|---|
| WBC (白血球数) |
3.3~8.6 | ×10^3/μL | 白血球は細菌などを貪食し、殺菌する働きや免疫情報を伝達する働きをしています。血液疾患や炎症性疾患の診断・経過観察などに用いられます。 |
| RBC (赤血球数) |
♂ 4.35~5.55 ♀ 3.86~4.92 |
×10^6/μL | 赤血球は骨髄でつくられ、細胞に酸素を運ぶ働きをしています。多血症などで増加し、貧血などで減少します。 |
| Hb (ヘモグロビンまたは血色素) |
♂ 13.7~16.8 ♀ 11.6~14.8 |
g/dL | 血液の赤い色は赤血球に含まれるヘモグロビンによるもので、赤血球の働きの中心的役割をしています。貧血の有無や血液疾患の診断・経過観察などに用いられます。 |
| Ht (ヘマトクリット値) |
♂ 40.7~50.1 ♀ 35.1~44.4 |
% | ヘマトクリットは、一定量の血液中に含まれる赤血球の割合を調べる検査です。多血症などで増加し、貧血などで減少します。 |
| Plt (血小板数) |
158~348 | ×10^3/μL | 血小板は出血した時に、出血を止める重要な働きをします。出血傾向の有無や血液疾患の診断・経過観察などに用いられます。 |
血液像
| 検査項目 | 基準値 | (単位) | この検査でわかること |
|---|---|---|---|
| 好中球 | 37.0~72.0 | % | 細菌などの体内異物の貪食や除去が主な役割です。細菌感染症や組織障害などで増加し、ウイルス感染症や血液疾患、膠原病などで減少します。 |
| 好酸球 | 0.0~6.0 | % | 寄生虫感染やアレルギー性疾患などで増加します。 |
| 好塩基球 | 0.0~1.0 | % | もともと数は少なく急性アレルギーや慢性骨髄性白血病などの腫瘍性疾患などでも増加します。 |
| リンパ球 | 20.0~50.0 | % | 主に免疫能を担っています。ウイルス感染症の一部やリンパ増殖性疾患などで増加します。 |
| 単球 | 0.0~14.0 | % | 主に免疫・炎症に関与します。 |
凝固検査
| 検査項目 | 基準値 | (単位) | この検査でわかること |
|---|---|---|---|
| PT (プロトロンビン時間) |
9.9~11.8 | 秒 | 血液の凝固反応に関係するたんぱく質「凝固因子」が正常に働くかを調べています。手術前検査や抗凝固療法の指標となります。また、凝固因子の多くは肝臓で造られるため、肝疾患の病態把握にも用いられます。 PTは外因系、APTTは内因系の凝固因子の働きを反映しています。Fibは、出血を止める糊の役目(フィブリン)の素となるたんぱく質で、急性炎症で増加することもあります。 |
| APTT (活性化部分トロンボプラスチン時間) |
25.0~38.0 | 秒 | |
| Fib (フィブリノーゲン) |
200.0~400.0 | mg/dL | |
| ATⅢ (アンチトロンビンⅢ) |
75.0~125.0 | % | ATⅢ活性は血管内の凝固反応を抑える働きを調べています。 |
| FDP (フィブリン/フィブリノーゲン分解産物) |
5.0以下 | μg/mL | FDPとDダイマーは、体内にできた血栓を溶かす「線溶系」の反応をみる検査です。これらは、血栓症の診断、特に全身の血管に微小血栓ができてしまう「播種性血管内凝固症候群(DIC)」の診断にも用いられます。 |
| Dダイマー | 1.0以下 | μg/mL |
骨髄検査
症状や末梢血所見から白血病などの血液疾患が疑われた場合には骨髄穿刺が行われ、骨髄塗抹標本(メイ・ギムザ染色)を作成し鏡検します。必要に応じて特殊染色も実施しています。
白血病とは
血液のがん(主として白血球、まれに赤血球、血小板などから発生することもある)です。血球を作る細胞(造血幹細胞)が、骨髄中でがん化して無制限に増殖し続ける病気です。白血病は大きく分けると急性白血病と慢性白血病に分類されます。
 |
【急性リンパ性白血病(ALL)の骨髄像】 幼若なリンパ系の細胞が増殖しています。 |
|---|---|
|
【急性骨髄性白血病(AML)の骨髄像】 幼若な骨髄系の細胞(骨髄芽球)が増殖しています。 |
|
【急性前骨髄球性白血病(APL)の骨髄像】 細胞質にアウエル小体という短い線のような構造物が束になって存在するファゴット細胞が出現するのが特徴です。 |
|
【慢性リンパ性白血病(CLL)の骨髄像】 小型のリンパ球(成熟したB細胞)が増殖しています。 |
 |
【慢性骨髄性白血病(CML)の骨髄像】 いろいろな成熟段階の骨髄系の細胞が増殖しています。また、好酸球(←)や好塩基球が増えるのが特徴です。 |
多発性骨髄腫とは
形質細胞が悪性化し単クローン性に増殖する疾患です。血清中にM蛋白という異常免疫グロブリンが増加し、その一部が尿中にも認められます。
 |
【多発性骨髄腫の骨髄像】 細胞質が青く染まり核周明庭を持つ異常形質細胞が増殖しています。 |
|---|
一般検査
一般検査は、尿定性、尿沈渣などの検査です。
尿定性検査は、蛋白・潜血・糖など体の異常を示す成分が尿中に出ていないか調べる検査です。
尿沈渣検査は尿を遠心してできた沈殿物(沈渣)を顕微鏡で観察する検査で、腎尿路系疾患の鑑別や程度を知るのに重要です。
尿を採るときには、できるだけ中間尿(※)の採取をお願いしています。
※中間尿とは:最初の尿は採取せず、排尿を止めずに途中の尿を採尿容器に採取します。最後の尿も採取せずに廃棄します。


尿定性検査 尿中の成分を調べます。
| 検査項目 | 基準値 | この検査でわかること |
|---|---|---|
| pH | 4.5~7.5 | 尿がアルカリ性~酸性のどの状態にあるのかを調べる検査です。pH7.0を中性としてそれより低値が酸性、高値がアルカリ性です。pHの値は体内の平衡を保つため1日のうちでも大きく変動します。持続性の酸性尿、持続性のアルカリ尿は病的と考えられます。アルカリ尿では腎盂腎炎、膀胱炎、尿道炎などが、酸性尿では飢餓、糖尿病などが考えられます。 |
| 尿比重 | 1.005~1.030 | 尿の濃縮具合を調べる検査です。腎臓は濃い尿や薄い尿を作ることによって体内の水分を調節します。1日のうちでも大きく変動します。 |
| 尿蛋白 | (-) | 尿中に蛋白が出ていないかを調べる検査です。健常人の尿にも蛋白は少量含まれていますが、通常の尿検査では検出されません。糸球体腎炎、腎不全などで陽性になります。 |
| 尿糖 | (-) | 糖尿病発見の手がかりになる検査です。糖尿病、腎性糖尿病、甲状腺機能亢進症などのホルモン異常などで陽性になります。 |
| ケトン体 | (-) | 糖尿病や糖摂取異常などを知るために行う検査です。糖尿病、下痢や嘔吐、飢餓(ダイエット)などで陽性になります。 |
| 尿潜血 | (-) | 尿中に血液が混入していないかを調べる検査です。腎臓や膀胱などの炎症・腫瘍、結石などで陽性になります。 |
| 尿ビリルビン | (-) | 肝・胆道系の病気の診断の手がかりになります。黄疸などで陽性になります。 |
| ウロビリノーゲン | (±) | |
| 亜硝酸塩 | (-) | 膀胱内に細菌による炎症がないかを調べる検査です。 |
| 白血球 | (-) | 腎尿路系に炎症がないかを調べる検査です。 |
尿沈渣検査 顕微鏡で尿中にどんな成分がどのくらい含まれているかを調べます。
| 検査項目 | この検査でわかること |
|---|---|
赤血球 |
腎・尿路系の出血性病変を示唆する重要な有形成分です。 |
白血球 |
腎・尿路系感染症など炎症性病変の存在を示唆する重要な有形成分です。 |
扁平上皮細胞 |
膣トリコモナスや細菌感染などによる尿道炎、尿道結石症、カテーテル挿入などによる機械的損傷後、前立腺癌のエストロゲン治療中などの場合に多く出現します。また、女性は尿路系に異常がなくても外陰部由来、膣部由来の扁平上皮細胞が赤血球や白血球、細菌などとともに混入します。 |
| 尿路上皮細胞 (移行上皮細胞)  |
膀胱炎、腎盂腎炎、尿管結石など腎杯・腎盂から内尿道口までの炎症、結石症、腫瘍、カテーテル挿入による機械的損傷を受けた場合などに認められます。健常人にも少数出現します。 |
尿細管上皮細胞 |
糸球体腎炎、ネフローゼ症候群、腎硬化症、ループス腎炎、嚢胞腎などの腎実質疾患患者尿に高率に認められます。また、腎虚血または腎血漿流量減少を来す病態や、種々の化学薬品および薬物などによって腎障害やアレルギー反応を起こした場合にも、高率に認められます。健常人にも少数出現します。 |
硝子円柱 |
健常者でも認められることもあり、とくに激しい運動後では出現頻度が高くなります。また、蛋白尿を呈する腎疾患や全身性の血流障害などでも認められることがあります。 |
細胞質内封入体細胞
 |
ウイルス感染症で認められることが多いが、ウイルス感染症以外でも膀胱炎、腎盂腎炎、尿路変更術後、腎薬物中毒などの非特異的な炎症時に出現します。 |
外来採血室
外来採血室では、患者さんの採血、尿、喀痰、便の受付や尿素呼気試験(ピロリ菌検査)などを行っています。
(1)採血について
診断の基となる重要な情報を得るために、採血が行われます。通常は、静脈から採血する静脈採血が行われます。
採血した血液からは、多くの情報(貧血、血液型、肝機能、腎機能、感染症の有無、各種腫瘍マーカー、悪性腫瘍遺伝子情報、その他の検査データ)を得ることができます。
外来採血の受付方法
外来採血室前の採血・採尿受付機に診察券を入れてください。
採血整理券(ピンク用紙)や尿コップが発行されますので、尿検査のある方は採尿を済ませてから採血整理券の採血番号が呼ばれるまでお待ちください。


診療前検査について
当センターでは迅速な診断による効率的な治療の開始、疾患の重症化の回避、当日結果報告による受診回数の低減などを目的として診療前採血を行なっています。
採血に関する注意事項
下記に示した注意事項の遵守にご協力をお願いいたします。
採血は、空腹状態で行なうことが多いですが、食事に影響される検査項目が含まれていない場合や、病状によっては食事をとってよいこともあります。採血前の食事については、主治医にお尋ねください。
食事を取らないように指示がある場合
- 採血前日の午後10時以降は、食物はとらないでください。
- 水やお茶は飲んでもかまいません。
ただし、以下のものは飲まないでください。
×スポーツドリンク、ジュース、コーラ、牛乳など糖分や脂肪を含んだもの
×アルコール
(アルコールはお酒に強い・弱いに関係なく、血中の中性脂肪を上昇させます。) - 発熱などで大量の発汗がある場合には、水やお茶などで積極的に水分摂取をしてください。
- 朝食をとらない分、適度な水分補給を心がけてください。
採血日の服装は腕が出せるように、きつい袖の服の着用は避けてください。
アルコール過敏の方は採血時にその旨、お申し出ください。
採血後の注意事項
採血後、5分ほど採血部位を圧迫してください。揉んではいけません。
採血当日に入浴してかまいませんが、採血部位を強く洗わないでください。
採血後に痛みがある場合は、主治医または、外来採血室のスタッフにご相談ください。
ご不明な点は主治医や外来検査受付にお尋ねください。
豆知識
食事の影響
血糖値:
食後30分位から上昇しはじめます。食後の血糖値が空腹時血糖値と判断される恐れがありますので、採血前に食事をした場合はお申し出下さい。
中性脂肪:
前夜の食事、前々日の食事で、多量の脂肪分を摂取することにより、一過性に上昇することがあります。なお総コレステロール、HDLコレステロールは直前の食事の影響は受けません。
過激な運動による影響
過激な運動で上昇する酵素:CPK(クレアチンキナーゼ)
筋組織に多量に存在し、随意筋とよばれる大きな骨格筋を激しく使う事により通常の10倍以上上昇することがあります。
(2)尿検査について
尿を調べることで腎機能や、尿路感染、異常細胞の有無などが分かります。
尿を採るときにはできるだけ中間尿(※)の採取をお願いしています。
※中間尿とは:最初の尿は採取せず、排尿を止めずに途中の尿を採尿容器に採取します。
採尿する量は、尿カップの25~50の目盛りを目安に入れてください。少なくとも25の目盛りまで入れてください。生理中の場合は、その旨、主治医にお伝えください。

(3)喀痰検査について
喀痰を用いて細菌感染の検査、細胞診検査を行います。
- 咳払いして喀痰を出しますが、黄色や緑色の粘りけのある固まりが喀痰です。
さらさらとした無色や白色の液体は唾液です。唾液だけでは検査材料には不適当ですので、できるだけ喀痰を含めて採痰してください。 - 喀痰は、採痰容器に直接出してください。(ちり紙などに取ってから採痰容器に入れない)
- 起床後日常生活を開始したときに喀痰は多く出ます。これは、寝ている間に気道にたまった喀痰が排出されるためです。喀痰があまり出ない方は、できるだけ起床直後に採痰するようにしてください。
- 細菌検査の場合は、喀痰は採痰容器に入れ冷蔵庫(4℃)で保存してください。
- 冷蔵庫で保存しても1日が限度です。喀痰を採取したその日か、次の日には中央処置室受付に提出してください。
- 細胞診検査の場合の蓄痰は、数日分の痰を専用容器に採取し、中央処置室受付に提出してください。
(4)便(潜血)検査について
糞便検査(便潜血)は、胃・十二指腸・大腸から出血しているかどうか、肉眼では見えないような微量の血液を検出する検査です。
- 採取量にご注意ください。
- 生理日に採便するのは避けてください。
- 痔疾のある患者さんは、主治医にその旨お伝えください。
- 採取が済みましたら、採取日当日、もしくは翌日に中央処置室受付に提出してください。
(5)尿素呼気試験について
尿素呼気試験は胃の中のピロリ菌感染を診断する検査です。
ピロリ菌(ヘリコバクター・ピロリ)は胃の中に生息している細菌です。
ヒトからヒトへ感染し、消化性潰瘍や腫瘍発生の原因のひとつと考えられています。
この菌は胃の粘膜の表面にくっついたり、粘膜の細胞の間に入り込んだりして、生息、増殖しています。 胃はその細胞表面を、粘膜と粘液でおおわれ、胃酸によって胃自体が消化されないようになっていますが、ピロリ菌はこの粘液の中に生息していて胃の中にある 尿素からアンモニアを作りだし、自分の身の周りの酸を和らげて生きています。 その結果、粘膜を傷害し、空洞化させてしまいます。そのため胃や十二指腸の粘膜が、胃酸の攻撃を受けやすくなり、胃炎や消化性潰瘍を発症します。この胃炎の一部から胃がんなどが発生する場合もあります。 また、消化性潰瘍はいったん治っても何度も再発を繰り返すことがありますが、ピロリ菌の除菌によって、治癒する症例も多くあります。
尿素呼気試験は診断薬を服用し、服用前後の呼気を集めて診断する精度の高い検査法です。 また、簡単に行える方法なので、除菌前と除菌療法後4週以降の除菌判定検査に推奨されています。
※注意事項:検査開始4時間前までに、食事を済ませてください。
病理検査室
生体検査、手術検体の病理診断
患者さんから採取された組織・臓器をパラフィンに浸透してパラフィンブロックを作り、そのブロックから厚さ3μm(3/1000mm)の切片を作製し、染色して顕微鏡で観察します。臨床検査技師が標本作製を行い、その後病理医による病理診断が行われます。この標本からは良悪性の診断の他、手術検体では腫瘍の大きさや広がり、悪性度などを調べ、病期や治療方針を決定する上で重要な役割を担っています。
また、乳癌におけるHER2や肺癌におけるEGFRなどのバイオマーカーを治療前に調べることにより、安全かつ有効な治療を患者さんに提供できるコンパニオン診断やがんゲノム診療にも病理診断は大きく関わっています。
 |
 |
 |
| 病理医による切り出し | 技師による標本作成 | 病理医による診断 |
|---|
手術中の迅速診断
手術中にリンパ節や断端(切除した組織の端)などの組織を凍結して迅速に標本を作製し、顕微鏡で観察して検体中にがんがあるかないかを術者に報告します。この結果によって術式が変更になることもあり、術中迅速診断は重要な役割の一つです。
 |
 |
 |
| 迅速が必要な部分の切り出し | ミクロトームによる薄切 | 染色後、病理医が診断・結果報告します |
|---|
病理解剖
患者さんが亡くなられた場合、ご遺族の了承のもとにご遺体の解剖を行います。
この病理解剖を通して、診断や治療の妥当性、死因などについて知ることができます。
細胞診断(細胞診検査室)
細胞診検査とは採取した検体にがん細胞ないかを探し出す検査です。主な検体の種類は、子宮頸部や子宮体部などの婦人科検体、乳腺や甲状腺、リンパ節などの穿刺吸引検体、体腔液(胸水や腹水)や尿、痰などです。
細胞診は体に大きな負担をかけることなく、早くて精度の高い検査ができます。また検体の一部を用いてHPV検査やEGFR検査を外注で行っています。
当センターではEUS-FNA(超音波内視鏡下穿刺吸引法)やEBUS-TBNA(超音波気管支鏡ガイド下針生検) 時に適切な検体採取を目指して臨床検査技師 が直接手術室や内視鏡室へ出向き、検体採取の介助や迅速診断を行うオンサイト細胞診も実施しています。これにより適切な検体採取や患者さんの負担軽減に大きく貢献しています。

遺伝子診断(遺伝子検査室)
遺伝子検査室では末梢血液を用いてWT-1検査を行っています。また、組織診で作製された標本からもFISH検査を行っています。
WT-1検査とは急性骨髄性白血病などで高発現しているWT-1遺伝子のメッセンジャーRNAを定量する検査で、白血病の治療効果判定や再発の早期診断などに役立っています。
FISH検査とは染色体の一部に蛍光物質で目印(シグナル)をつけて蛍光顕微鏡で観察することで、特定の染色体の数的異常や質的異常を調べる検査です。この検査により組織診の確定診断や分子標的治療薬の選択が可能となります。当センターでは主に乳癌や胃癌のHER2-FISH、軟部腫瘍のFISHなどを行っています 。
 |
 |
| WT-1 検査風景 | PCR検査風景 |
|---|

